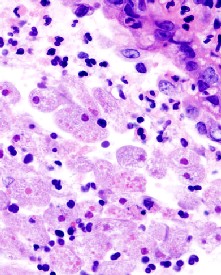
Amoebic dysentery

Fluxes/Diarrhea and Related Illnesses Page Menu: 1 2 3 4 5 6 7 8 9 10 11 Next>>
Treating Fluxes in the Golden Age of Piracy, Page 3
Causes of a Flux
"Both Ships [the Swallow and Weymouth] came to the Isle Del Principe the end of July, 1721, where we felt dreadful Effects from the excessive Heats and Irregularity of the

Artist: Louis Le Breton
Careening the Zélée aground in the Torres strait (18th c.)
Seamen, during our Careening, for although we arrived very healthy, the Island furnishing Palm-Wines and the means of debauching at easy Rates, and our Tents giving opportunity; they soon run into Excess, which brought on an epidemical malignant Fever... [we] got under Sail and left the Island... [but] our Fevers for want of Necessaries turned in many to Fluxes, and pursued us, tho’ with less Cruelty. The Weymouth, who brought out of England a Compliment of 240 Men, having at the end of the Voyage 280 dead upon her Books." (John Atkins, A Voyage to Guinea, Brazil and the West Indies, p. 138-9)
If there is one thing that appears clear about the causes of fluxes at this time, it is that those causes were not clear in the minds of the surgeons and physicians. Like they did with scurvy, the medical men of the period blamed anything and everything as being the root of a diarrhea or dysentery. Re-reading Atkin's quote above, you will notice that he suggested that the heat, overeating and drinking of palm wine were all to blame for the fever which turned into a flux.
Modern histopathologic image of
amoebic dysentery
In fairness, diarrhea actually has many causes. Bacteria associated with contaminated food and drink can cause both diarrhea and dysentery.1 An amoebic form of dysentery exists which is spread through infected food and drink.2 Contagious viruses can be at the root of a diarrhea, spread though direct and indirect contact (via food preparation and such) with those infected.3 Diarrhea can also be a bodily response created by food intolerance, diseases such as bowel problems, diabetes, hyperthyroidism or even just plain old stress!4
Of course, none of the preceding causes were well understood during the late 17th and early 18th centuries during the golden age of piracy, so period surgeons and physicians had rely on observations and the words of the ancient physicians.
With this in mind, let's look at the multiple causes of fluxes identified in period documents.
1 Joanne Barker, Coping With Diarrhea and Digestive Distress: What Causes Diarrhea?, WebMD, gathered 2/16/13 & wikipedia, Shigellosis, gathered 2/16/13; 2 Christian Nordqvist, What Is Dysentery? What Causes Dysentery?, Medical News Today, gathered 2/16/13; 3 Barker, ibid.; 4 Ibid.
Causes of a Flux: Food
"About this time Robert Barrow was taken with a grievous belly-ache, after which he fell into a violent flux. Several of our people also were taken with the

Photo: Rei
The innocent pompion (pumpkin) in the foreground
belly-ache and great scouring [diarrhea], all which was chiefly occasioned by our unreasonable eating and not governing ourselves therein. Our chief diet was hominy, herbs and pumpions, having not much meat; which should have destroyed ourselves; but we had the best the place afforded." (Jonathan Dickinson, Jonathan Dickison's Journal or God's Protecting Providence, p. 65)
Food is probably the most frequently-blamed cause of diarrhea in the period journals, which is appropriate given that food often is the source of a diarrhea. Anyone who has traveled to a location where the food and the bacteria that food contains is not familiar to their system can attest to this.
Sailors and pirates were travelers, so they were subject to all the vicissitudes of their profession. Jonathan Dickinson bemoans the fate of a small group who were shipwrecked in Florida in 1696. Throughout the course of his account, they made their way along the eastern coast to their original destination - Philadelphia! This is why they had to resort to "the best the place afforded", which may have caused them to suffer diarrhea.
Causes of a Flux: Food- Poor Diet
Diarrhea-causing food is identified by several period medical authors. William Cockburn explains that one "Cause of a Loosness, alledged by Physicians, is unwholsome Food. Our Food, or Aliment, is then said to be unwholsome, when it either affords us little Nourishment"1. He goes on to explain that some foods are bad because they cause a lack of sweat, indicating that they may lead to a flux. For example, he tells us that the "Body commonly perspires a third less, than at other times, by eating Mushrooms and Swine's Flesh."

Photo: Madjack74
The innocent mushroom - The Prince or Agaricus Augustus
2 German surgeon Matthias Gottfried Purmann blames poor diet, suggesting that "[t]o many Persons there happen Spontaneous Loosenesses ...[caused] by committing Errors in their Diet, eating Fat and Greasy Provisions"3
Dysenteries or bloody fluxes were also blamed on bad diet. Military surgeon Raymund Minderer warns that "Bloody and other Fluxes are very frequent, caused by an irregular and ill dyet"4. Sea surgeon John Moyle tells us "as to the Dysenteria, 'tis caused by vitious [impure] Dyet, together with lying in the wet and cold, which generates the unnatural Choler that gnaws and frets the tender Tunicles [interior vessels] of the Intestines, making Ulcers and Bleeding"5. (You will note that Moyle blames several symptoms, some of which we will discuss in more detail shortly. )
Sea surgeon John Woodall goes to what he feels is the heart of the matter, placing the blame for fluxes at the feet of overeating and incomplete food preparation. "Let such as feare the flixe [flux] not overgorge themselves, for the overcharging and straining of the stomake oft bringeth this sicknesse, chiefly when the body is weake, as also if the foode taken be crude or not well boyled or rosted, and meerely fresh without any salt."6 In fact, Woodall has a a point there, given that raw fruits and vegetables that contain diarrhea-causing bacterias can be a source of a flux.
Edward Barlow, ever ready to register his complaints against his masters and the poor food on the ships, explains that in 1672,

Photo: Tamorlan
Salt Pork - The same meat as bacon without curing.
[W]e had several of our men sick of the 'fflukes' [flux], and I myself being very bad; the sea being an uncomfortable and bad place for sick ...[who] having small means to comfort themselves with, for there they cannot run and fetch what meat and drink they think will do them good. There they want both fresh meat and drink of all sorts, with both fruits and roots, which the sick on land do not lack to give themselves comfort with, and we having no other thing to eat and drink, to restore health, and comfort ourselves with, unless we can eat a piece of hard biscuit cake, or a piece of old salt beef or pork, and maybe both stinking and rotten, having lain in pickle one year or two7.
Interestingly, in his previous quote, John Woodall blamed a lack of salt as being part of the cause while Barlow suggests that it is 'old salt beef or pork, and maybe both' that may be to blame. Today some people suggest that excess salt can cause Osmotic Diarrhea by allowing excess water to be retained in the stool, although not everyone agrees. Even withouth that, we'd have to give Woodall the edge since he was a surgeon while Barlow was just an ordinary sailor (not to mention being something of a whiner.)
Another common food-based cause of fluxes was thought to be a sailor's change in diet from that to which he

Native bringing local food to a ship. Taken from
Naaukeurige versameling der gedenk-waardigste
zee en land-reysen na Oost en West-Indiën, by
Pieter van der Aa (1707)
was accustomed to local foods. As previously noted, Raymund Minderer blames an 'irregular diet' for both regular and bloody fluxes. Edward Barlow ascribes bloody fluxes to the death of men near Java where seamen with "cold country constitutions as English and Dutch... leaving off their native country victuals... and eating the hot [probably spicy] country provisions, which are quite contrary to our natures... [and] changing all our victuals and drink upon a sudden, it changeth our flesh into another nature. ... [I]t is a thousand to one if he catch not some disease or another presently, the bloody 'flukes' being the rifest".8
John Woodall explains the problem with fluctuations in diet, noting that "Sea-men in long voyages, and namely in hot countries, chiefly when after short and hard allowance they shall happen on the sodaine [sudden] to get great store of rawe fruit, fresh meat, flesh or fish or any other great change of pleasant dyet, in which cases reason and judgement, as the principall helps are to be used" to avoid contracting a bloody flux.9 It is most interesting that Woodall correctly identifies raw food as a source of dysentery, although given his tendency to provide long lists of possible causes for various ailments, it may not be quite as amazing as it otherwise might have been.
Causes of a Flux: Food - Fruit
One of the main food-based sources to blame for fluxes according to period sources is fruit. Indeed, fruit can be a cause of a diarrhea or dysentery, because it is frequently eaten raw, allowing the offending bacteria free access to a victim's digestive system.
Edward Barlow explained that sailors "eating many times much of their sweet luscious fruits ...[so that] if a man be not very moderate and careful" he may come down with a flux.10 Sea physician Thomas Aubrey says he believes diarrheas result "from an immoderate use of Fruits, viz. Bonnanas, Pine-Apples, &c. because I have very frequently

The innocent banana - from Nouveau Voyage aux Isles
de l'Amerique by Jean-Baptiste Labat, V.4, p. 361 (1722)
remarked that our white People, who made little or no use of those Fruits... were never affected with it: They do not rightly digest in their Stomachs, but leave a kind of viscid glairy [slimy, viscous and transparent] Matter behind them"11.
William Cockburn agrees, stating
that unripe Fruit very commonly Causes a Diarrhœa. Even Countries not otherwise subject to the Disease, feel these Effects of Fruit in the Season. France, viz. Spain and Italy, give many Examples of Fluxes in the Grape-Season, in time of the Vintage, and when the Wine is drunk very new: then a Loosness is very common, and very mortal. The Reason is obvious; for the Juice of Fruit gives a Quantity of serous Parts to the Blood, as well as increases its Lentor [viscousness]. Now the Quantity of Blood encreased with a Lentor lessens Perspiration, and occasions a great Quantity of Lympha to be secreted in the Glands of the Guts; which extraordinary Secretion alone, while their peristaltick Motion is natural, we find is the Essence of a Diarrhœa.12
He really has it in for substances that reduce sweating!

Photographer: Tauʻolunga
The innocent (but ugly) tamarind
Three authors identify specific fruits that they feel cause diarrhea. Naval physician James White specified the cause of a bloody flux shipboard as "unripe Lemons (which they bought at Lisbon) with which they made great Quantities of Punch, which gave the Sherbet a harsh bitter Taste, that cou'd not be avoided, because
there was so little Juice in 'em."13
Woodall blames the sailor's habit of eating too many tamarinds for causing a diarrhea. He does this not once, but twice. First he warns that if a surgeon "feare a fluxe of the belly, or have a weaknes in the raines [reins - kidneys], let him not eat too much of the Tamarinds."14 He later explains that "eating Tamarindes brought from Bantham if you use them overmuch by their acrimony may easily cause a fluxe, although their vertues in preserving from the Scurvie, are unreproveable and very good in deede."15
Cockburn, being ever concerned about sweating, cites Sanctorius, an author who studied the way the human body uses food through direct experimentation. Cockburn thus advises that "Melons, says Sanctorius, perspire so very little, that they keep off a fourth Part of the common Perspiration."16 This naturally leads to a flux as he explained previously.
1 William Cockburn, The Nature and Cure of Fluxes, p. 61; 2 Cockburn, p. 63; 3 Matthias Gottfried Purmann, Churgia Curiosa, p. 331; 4Raymund Minderer, A Body of Military Medicines Experimented, Volume 4 of Paul Barbette's, Thesaurus Chirurgiæ, The Fourth Edition, p. 70; 5 John Moyle, The Sea Chirurgeon, p. 171; 6 John Woodall, the surgions mate, p. 214; 7 Edward Barlow, Barlow's Journal of his Life at Sea in King's Ships, East and West Indiamen & Other Merchantman From 1659 to 1703, p. 214; 8 Barlow, p. 209; 9 Woodall,p. 208; 10 Barlow, p. 209; 11 Thomas Aubrey, The Sea-Surgeon or the Guinea Man’s Vadé Mecum., p. 74; 12 Cockburn, p. 65; 13 James White, De recta sanguinis miffione: OR, New and Exact Observations OF FEVERS, p. 9; 14 Woodall, p. 186; 15 Woodall, p. 214; 16 Cockburn, p. 63
Causes of a Flux: Liquids
"I have known that the Excess of Wine hath caused Fevers, and the Eager Beverage Wines that we usually drink in the Streights hath caused Fluxes". (John Moyle, The Sea-Chirurgeon, p. 181)
Liquids, particularly water and fruit juices, are well-known causes of diarrheas. Period surgeons and sailors identified two liquid causes: water and alcohol. Each have the potential to cause fluxes, so let's look at them.
Causes of a Flux: Liquids - Water
"Don't drink the water!" is a common admonition to travelers

Pirates carrying barrels ashore, from The
Pirates Own Book by Charles Ellms (1837)
heading for the Central and South America because of the bacteria untreated local water can contain. Traveling during the golden age of piracy would have made this a difficult proposition given the inability to treat water or carry enough from home on voyages that lasted months and even years. Ships were dependent upon local water to continue their voyage and had no real way of treating it to remove the bacteria that caused diarrhea (or any understanding that it was even there).
Curiously, none of the period surgical manuals identify water as being the source of a flux. Our only two period references for this come from the seamen themselves. Although water isn't the only suspected culprit in his narrative, Edward Barlow does tell of a man who "died of the bloody 'fflukes' [flux], it being a disease that many die of in and about this island [near Java]... [due to] leaving off their native country victuals and drink, and drinking altogether water"1. Careful reading of that sentence reveals that Barlow believes that part of the problem in this case was drinking 'native country' drink (including water) in addition to drinking nothing but water, and forgoing alcohol.
The second account of diarrhea-causing water comes from privateer Woodes Rogers who reported that on July 21, 1710, "Many of our Men fell ill of Fevers and Fluxes, occasion'd, as I was inform'd, by their drinking the Water upon the Island [Horn Island, Chile]."1 It's not clear who 'inform'd' Rogers of this cause; it may have been one of the surgeons aboard, it may have been colorful ship's physician Thomas Dover or it may have been one of the men. If it were one of the surgeons or Dover, they would have been the only medical man to make this connection during period from my reading.
Causes of a Flux: Liquids - Alcohol
While they didn't give water much attention, the period medical men mentioned alcohol
several times as being the cause of a flux. Even sailor Barlow informs us that drinking "the sour 'befraiage' [beverage - probably referring here to a punch or daily ration of watered down ale and wine] ...many times in hot weather bringeth a

The Source of the Trouble
man to the 'flukes' [flux]"3. German surgeon Matthias Gottfried Purmann blames 'spontaneous looseness' on eating bad foods and "drinking after them New, Muddy, Thick, Nasty Beer or Ale."4 Sea surgeon John Woodall concurs with Purmann, noting that "sometimes it [diarrhea] happeneth here in our Countrie, as some English Writers affirme, by little drinking of beere or ale, and sometimes it commeth by drinking too much wine"5.
Woodall is actually on to something here. In the abstract to a paper on the topic, two researchers explain in typical higher education gobbledygook that "Small bowel motility and transit may be abnormal in both acute and chronic alcoholics, and colonic propulsive motility is increased after acute administration of alcohol. Any, or all, of these changes in gastrointestinal functions may contribute to diarrhea in acute binge drinkers and chronic alcoholics."6 This translate roughly into: 'alcoholics may experience diarrhea after extensive drinking.'
Continuing in the wine vein, sea physician Thomas Aubrey weighs in on the subject. "I believe it [diarrhea] generally proceeds on this Coast [Africa], from ...Palm Wine &c. because I have very frequently remarked that our white People, who made little or no use of... [that] Liquor"7. So here we have a combination of wine and the fact that Europeans weren't used to having a particular type in their diet.

Edward Low's Men Drinking, from Histoire
der
Engelsche zee-roovers (1725)
William Cockburn actually blames alcohol for dysentery, giving a confusing explanation that might make our modern researchers proud.
Spirituous Liquors are a Cause, very near, of the same Kind; for spirituous Liquors rarify the Blood, and encrease its Velocity. By the first, spirituous Liquors are a Cause of a Dysentery, as in the preceding Case. By the second, the Blood being impelled with a greater Velocity, distends its Vessels in a Proportion compounded of the rarified Quantity of the Blood, and its Velocity. On this Consideration spirituous Liquors are a more powerful Cause of a Dysentery than hot and sultry Air.8
Despite his verbose presentation, we have to give Cockburn credit here; he identifies alcohol as a blood-thinner, noting that it rarefies the blood. In fact, even a little alcohol can have this effect.9 The explanation that Cockburn follows with may be a bit dubious, but it is pretty good work on his part considering what was understood about anatomy at the time.
1 Edward Barlow, Barlow's Journal of his Life at Sea in King's Ships, East and West Indiamen & Other Merchantman From 1659 to 1703, p. 209; 2 Woodes Rogers, A Cruising Voyage Round the World, p. 208; 3 Barlow, p. 53-4; 4 Matthias Gottfried Purmann, Churgia Curiosa, p. 331; 5 John Woodall, the surgions mate, p. 242; 6 Toshimi Chiba & Sidney F. Phillip, "Alcohol-related diarrhea", Originally published June 6, 2006, gathered from Wiley Online Library, 2/17/13; 7 Thomas Aubrey, The Sea-Surgeon or the Guinea Man’s Vadé Mecum., p. 74; 8 William Cockburn, The Nature and Cure of Fluxes, p. 272-3; 9 About.com, Alcoholism, "Alcohol Can Act as a 'Blood Thinner'", gathered 2/17/13

